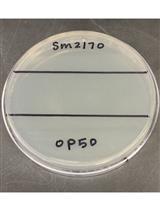
Assessment of Caenorhabditis elegans Competitive Fitness in the Presence of a Bacterial Parasite

- Protocols
- Articles and Issues
- About
- Become a Reviewer
Past Issue in 2018
Volume: 8, Issue: 16
Biochemistry
Modifying Styrene-maleic Acid Co-polymer for Studying Lipid Nanodiscs by Direct Fluorescent Labeling
Deoxycholate Fractionation of Fibronectin (FN) and Biotinylation Assay to Measure Recycled FN Fibrils in Epithelial Cells
Immunology
Identification and Quantitation of Leukocyte Populations in Human Kidney Tissue by Multi-parameter Flow Cytometry
Microbiology
Liposome Flotation Assay for Studying Interactions Between Rubella Virus Particles and Lipid Membranes
CRISPR/Cas Gene Editing of a Large DNA Virus: African Swine Fever Virus
Delivery of the Cas9 or TevCas9 System into Phaeodactylum tricornutum via Conjugation of Plasmids from a Bacterial Donor
Microfluidics-Based Analysis of Contact-dependent Bacterial Interactions
In vivo and in vitro 31P-NMR Study of the Phosphate Transport and Polyphosphate Metabolism in Hebeloma cylindrosporum in Response to Plant Roots Signals
Random Insertional Mutagenesis of a Serotype 2 Dengue Virus Clone
Assessment of Caenorhabditis elegans Competitive Fitness in the Presence of a Bacterial Parasite
Neuroscience
Studying the Role of Microglia in Neurodegeneration and Axonal Regeneration in the Murine Visual System
Trace Fear Conditioning: Procedure for Assessing Complex Hippocampal Function in Mice
Image-Based Analysis of Mitochondrial Area and Counting from Adult Mouse Dopaminergic Neurites
Plant Science
Pollen Germination and Pollen Tube Growth of Arabidopsis thaliana: In vitro and Semi in vivo Methods
An Inexpensive and Comprehensive Method to Examine and Quantify Field Insect Community Influenced by Host Plant Olfactory Cues
Stem Cell
Generation of Human Mesenchymal Stem Cell 3D Spheroids Using Low-binding Plates
Systems Biology
Quantitative ChIP-seq by Adding Spike-in from Another Species
Correction